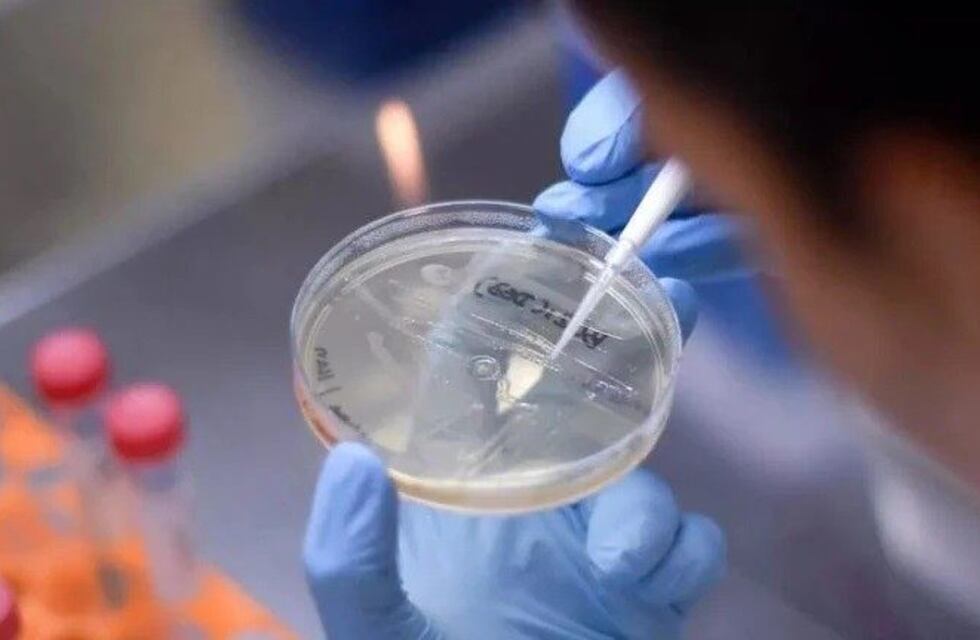
Los vecinos de Jaime Prats vuelven a respirar tranquilos

La población de Jaime Prats, uno de los distritos de San Rafael, volvieron a la normalidad y reina tranquilidad en la comunidad ya que se supo que los resultados de Covid-19 en los familiares cercanos a Mario Echeverría, resultaron negativos.
El hombre de 74 años, había ingresado al sistema de salud pública el martes 6 de abril como caso sospechoso de coronavirus y tres días más tarde se confirmó que era positivo. Echeverría tenía como patología de base un cáncer fulminante de pulmón y Epoc. Lametablemente falleció el pasado miércoles 15.
Desde que el diagnóstico de Echeverría fue coronavirus, un sinfín de teorías se tejieron pensando en determinar como pudo llegar el virus hasta el poblado rural (distante a 75 kilómetros de San Rafael ciudad).
Sin embargo la duda persiste ahora, más que nunca.

De las más de 60 personas que fueron puestas en estricta cuarentena, entre el viernes y el lunes se tomaron 14 muestras a las personas que estaban viviendo con el hombre y familaires directos que tuvieron contacto estrecho, todas ersultaron negativas para Covid-19, confirmaron desde el área de Salud en San Rafael.
En cuanto al resto de los aislados, singuen sin mostrar síntomas compatibles con coroanvirus A partir de ahora, contando desde el día que Echeverría fue internado y aislado en el hopistal Enfermeros Argentinos de General Alvear (es el mas cercano a Jaime Prats), las familias ya estarían en condicones de retomar su vida normal, siemrpe respetando los límites del aislamiento social y obligatorio que deben cumplir todos los argentinos.